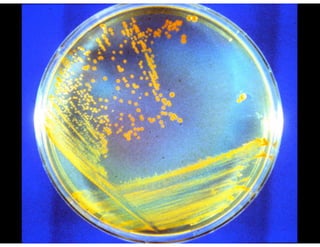

This document discusses the need for gifted education to evolve for the 21st century. It argues that students today need skills like creativity, collaboration, critical thinking and problem solving to succeed in a world driven by technology. Traditional education focused on memorization is no longer sufficient. The document advocates integrating technology into learning, allowing students to work on real-world problems, and cultivating skills beyond just knowledge like asking important questions and communicating answers.